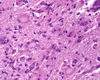
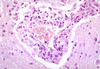

Exam 2 Path II Flashcards
What can occur to the aorta during excitement, physical activity (racing horses), and stallion breeding?
Aortic rupture
Which tickborne disease enters the brain via a “trojan horse” and results in Acute polioencephalomyelitis, Neuronal degeneration, neuronophagia, Lymphocyte cuffing, gliosis & meningitis?

Louping-ill (Flavivirus) - common in sheep
Dilated cardiomyopathy is seen in _______. Which breed are most susceptible?
Dogs, especially males
Larger dog breeds like:
- Doberman pinschers
- Portuguese water dogs
- Dalmatians
- Saint Bernards etc.,
What parasite is highly zoonotic in people that ingest undercooked meat due to the formation of cycts in the muscles and heart (parasitic myositis)?
Trichonella spiralis
In cattle, myocardial lymphosarcomas are associated with what?

enzootic leukosis
Lamb. Mdx? Etiology?

Cyclopia/Synophthalmos
Incomplete seperation of the orbits during embyrogenesis
Etiology: Veratrum Californicum ingestion on day 14
Determine cause via thourough history
Mdx?

Entropion and secondary trichiasis
Which of the following components of the CNS are least sensitive to hypoxia:
- Neurons
- Astrocytes
- Oligodendrocytes
- Microglia & Vascular endothelium
Microglia & Vascular endothelium= Mesoderm origin
All others are ectoderm origin and sensitive to hypoxia
What are 3 ways that viruses enter the brain?
- Haematogenous via BBB or choroid plexus- usually via trojan horse
- Replication in vascular endothelium (CAV, BMCF, EHV-1, FIP) –> vasculitis
- Neural Routes (Rabies, Borna, ADV)
What kind of brain lesions due parasites usually create?
inflammatory and space occupying
T/F: Hyperemia alone does not necessarily indicate conjunctivitis?
True
What are common organism in septic emboli in the CNS?
- Cattle – Actinomyces/Trueperella pyogenes, Haemophilus somni, Staph aureus
- Lambs – staph aureus (tick pyemia)
- Horse- strep equi
- Dog- staph aureus
MDx?

Nodular adrenocortical hyperplasia
senile change
Thyroid hyperplasia (goiter) will result in….
a. hyperthyroid
b. Euthyroid
c. Hypothyroid
b. Euthyroid & c. Hypothyroid
What plants/products contain thiaminases and cause CCN?
- Braken fern (Pteridium) intoxication in horses
- Male fern (Felix mas) and Molasses/Urea toxicity in cattle
- Cooked meat (thiamine is heat labile) in dogs/cats
- Fish diets in foxes/mink/cats - Chastek paralysis with polioencephalomalacia (below)

What is the term for phagocytosis of neurons by microglia/monocytes?

Neurophagia
What three circulatory bypasses/shunts are present during fetal development?
Ductus venosus - bypasses the liver
Foramen ovale- bypasses lungs (R atrium to L atrium)
Ductus arteriosus- bypasses lungs (Pulmonary a. to Aorta)
What is it called when acute cardiac dysfunction causes collapse and unconsciousness (due to abnormal heart rhythm, defective heart valves, etc) ?
Cardiac syncope
What lesions might you find as a result of renal secondary hyperparathyroidism?
Metastatic calcification,
fibrous osteodystrophy
hypercalcemia
Mdx? Sequela?

Ciliary (Iridociliary) adenoma/carcinoma
Sequela = Glaucoma, hyphema, retinal detachment
DOGS >>>>>> cats
Most benign
What is a gemistocyte?
***KNOW THIS***
Swollen astrocytes- cytoplasm contains pink “glassy” material
What is a Dysautonomia? and what disease causes it in horses? dogs/cats?
Dysautonomia- degeneration of neurons in a ganglion= see chromatolysis
Horses= Grass Sickness
Cats/Dogs= Heriditary Key Gaskell Syndrome

In dogs, the majority of pituitary adenomas are active and from what part of the gland?
pars distalis or pars intermedia
pars distalis
What cells consist of the neuroglia (supporting cells within the brain)?
–Astrocytes
–Oligodendrocytes
–Ependymal cells
–Microglia
Why does a detached retina have to be reattached ASAP?
if not, the retinal will undergo retinal degeneration and atrophy
MDx?

Hyphema
Blood in the anterior chamber - usually due to vascular lesion or disorder of hemostasis
consequence = blindness, retinal detachment, glaucoma

What is the most common metastasis involving the eye (especially in cats)
Uveal lymphoma
thickened pallor of uvea - difficult to distinguish from uveitis

What clinical feature is seen with congenital hydrocephalus?
Doming of Skull
Common in toy breed dogs

T/F: Cardiac muscle generally undergoes regeneration
FALSE!!!
Cardiac muscle generally has no regeneration capacity.
After injury, Necrotic debree is phagocytosed by M0 and the area is healed by fibrosis
In dogs, adrenocortical tumors mostly arise from what part of the adrenal gland?
zona fasciculata
What is the etiology of focal bilaterally symmetric encephalomalacia (Cerebrospinal angiopathy of swine)?
Edema disease (enterotoxemic colibacillosis) - verotoxin causes endothelial cell injury
When do uterine artery ruptures commonly occur?
In old mares with LOW SERUM COPPER levels during parturition
What do you call inflammation of the uvea, retina and vitreous?
Endophthalmitis
T/F: insulinomas are common in dogs and ferrets, and they are typically metastatic
True =( Be sure to provide edges in biopsy
AKA pancreatic islet cell carcinoma
What is Hydranencephaly?
absence of cerebral hemispheres, may get CSF-filled sacs

Hemopericardium is a sequela of what?

ruptured atrial hemangiosarcoma
What is occur in the picture?
Vasculitis
Light pigmented animals. MDx?

Corneal Squamous cell carcinoma
lack pigment
What is the etiology of this lesion (bilateral, symmetrical, Cavitation/gelatinous subcortical white matter)?

Copper deficiency during 100-120 days of gestation = Congenital Swayback
Due to failure to produce proper myelin (Cu is needed for myelin stability and for cytochrome oxidase and superoxide dismutase)
May also see Hydranencephaly/hydrocephalus and wallerian degeneration of spinal cord
Most common in mild winters (no diet supplementation) or if soil is rich in molybdenum/sulfates that interfere with Cu.
Delayed swayback = low copper in milk. no gross lesion in brain but Chromatolysis of neurons in red nucleus and brainstem nuclei as well as spinal cord lesions. CS seen at 1-2 months of age.
Acute delayed swayback= adult sheep- cerebral oedema- may or may not be due to cooper deficiency
T/F: Lymphosarcomas are usually multicentric and can be considered a possibility in any organ in any animal

True

Humans get neurocysticercosis by ingesting ________
Taenia solium eggs (from human (DH) feces)
What clinical signs can you see with hypoparathyroidism?
Tremors, Tetany, and Muscle hyperexcitability due to low Ca and high P
RARE- due to somethings that wipes out the parathyroid gland
The Fibrino-suppurative, hemorrhagic lesions centered on blood vessels in Thrombotic Meningoencephalitis (TME, TEME) are due to what pathogen?

Histophilus somni in feedlot cattle

Hypertrophic cardiomyopathies is most common in _______
Cats

Birsket edema in cattle typically indicated what disease?

Right CHF
What is the signifigance of this lesion? What species is it most common in?

Congenital valvular hematocyst
Incidental fiding - does not produce any clinical signs
Common in cattle
usually disappears with age
Abundant eosinophils in the perivascular spaces within the first 48 hours is pathonomonic in pigs for what disease?
Salt Poisening
Also see Edema, laminar necrosis (CCN) and neuronal changess
High intracelular Na –> intracellular edema
increased vascular permeability–> extracellular edema
Neurons synthesize eosinophil chemotactic
Must return water slowly to patient to prevent excess edema

What reversible neuron response to injury consist of swelling of cell body and dissolution of the nissl granules with margination of the nucleus?

Chromatolysis
———————-
Non-specific cause (eg injuries to axons, overstimulation/deficiencies)
Seen in EMN, dysautonomias, copper def,
What is the normal thickness peportion between the right and left ventricle wall?
1:3 to 1:4
What are 6 causes of Retinal degeneration & atrophy?
- Senile change
- Inherited metabolic defect in photoreceptor cells (rods and cones) = PRA, SARD
- Toxicity = baytril in cats
- Metabolic deficiencies= taurine, vitamin A
- Increased IOP (glaucoma)- pressure decrease blood supply
- Retinal detachment
How would you describe this? What does it cause?

Anterior synechia –> secondary glaucoma
What will you see with richettsial diseases in the brain (RMSF and Ehrlichiosis)?
Inflammation!!!
Rickettsia rickettsi (RMSF): is characterized by vasculitis. Canine Ehrlichiosis: causes a non-suppurative meningitis/ meningo-encephalitis
Where do septic emboli in the CNS like to localize?
In the Cerebrum at the grey/white matter junction
Primary pathogens are rare to cause conjunctivitis, but in cats there are three exceptions.
What are these primary pathogens in cats ?

- FHV-1
- Chlamydophilia felis
- Mycoplasma felis
What forms the choroid plexus?

Outpouching of ependymal cells in a core of CT containing blood vessels
Aortic stenosis results in compensetory concentric hypertrophy of the ______ventricle and post-stenotic dilation of the aorta
Left
Name the tumor!

choroid plexus tumor
Due to location- associated with the ventricles

Canine melanomas of the conjunctiva are considered _______ (malignant/benign)

malignant
Uveal melanoma= benign in dog
hair skined melanoma= benign in dog
What accopanies optic nerve hypoplasia/atropy?
primary retinal lesions (lack/loss of ganglion cells)
In a cushing patients, What skin condition is this most likely?

Calcinosis cutis
Van Kossa stain would show calcium
Large tumors of the pituitary that put pressure on the pars nervosa typically cause what disease?
Diabetes insipidus - interference with ADH transport to nervosa
What lesions are associated with all TSE diseases?
Vacuolation of neurons & neuropil
Dysfunction/loss of neurons
Astrocytosis
Accumulations of disease associated (resistant) prion proteins (PrPd/ PrPsc)
No immune response

Chicken. Name the disease!

Marek’s Disease-Lymphosarcoma
Lymphoid infiltrates in peripheral nerves, eyes, etc.

Which of the following are NON-reversible responses to cardiac injury? (pick all that appy)
- Fatty Defeneration and Infiltration
- Vascular degeneration
- Myocytolysis
- Lipofusin
- Neoplasia
- Necrosis
Lipofusin, Neoplasia & Necrosis
What virus in cats induces a Pyogranulomatous reaction centering on vessels of leptomeninges and neuropil that induces a vasculitis and immune complexes/fibrinoid necrosis?

Coronavirus- Dry Feline Infectious Peritonitis

What is the pathogenesis of pancreatic islet cell vacuolar degeneration?
insulin resistance –> hyperglycemia –> long term overstimulation of Beta-cells –> intracellular accumulation of glycogen –> vacular degeneration of beta cells –> insulin deficiency and more severe diabetes mellitus
What is the term for necrosis of corneal epithelium and stroma, usually due to innocent bystander injury from leukocyte in response to a rapidly progressing bacterial/fungal infection

“melting ulcer” - Keratomalacia
In dogs, which is more common: thyroid (follicular cell) adenoma or carcinoma?
carcinoma
Myocarditis often is the result of a _________ infection
hematogenous
Thickened pericardial sac, diaphramic adhesions, fibin covered epicardium, reticulitis and reluctance to move is common symptoms of what disease in cattle?

severe hardware disease
What is a common cause of Canine Coronary atherosclerosis?

****_Hypothyroidism *_***

What do you call lens-induced uveitis due to leakage of lens protein from a hypermature cateract?
Phacolytic
What cells develop and maintain myelin in the CNS? Where can they be found? And what virus causes primary demyleination?
Oligodendrocytes
Found between myelin sheaths or around neurons
CANINE DISTEMPER = primary demyleination

Which herpes virus associated with pigs (but can infect cattle and dogs) causes a ganglioneuritis, neurophagia, intranuclear inclusions, perivascular cuffing, gliosis, extreme pruritis (mad itch) and pharyngeal paralysis?
Aujeszky’s /Pseudorabies/ Swine Herpes Virus 1
Are TT4 levels increased in dogs with follicular cell tumors?
Nope, cells are too undifferentiated
Micro tumors of the pituitary commonly lead to what disease?
Cushings- Hyperadrenocorticism (ACTH producing chromophobes)
most common in dogs, horses and lab animals
What is the etiology of this lesion? The cat also had a URT and nasal infection.

Cryptoccocus neoformans (cryptococcal meningo-encephalitis)
Characteristic gellatenous punched out area in the brain that is glissening due to the components of the thick cell wall.

Vitamin E deficiency, ionophore toxicity (monensin, lasalocid), gossypol/cottonseed toxicity (pigs), and uremia (dogs and cats) are the more commonly seen causes of what?
Myocardial necrosis and mineralization
Mdx?

Eyelid agenesis - missing segment of eyelid
Which viruses cause polioencephalomyelitis with subtle perivascular cuffing and gliosis in horses?
Eastern, Western and Venezuelan encephalomyelitis viruses, family Togaviridae, genus Alphavirus.
What is the most common disease of the lens?
Cataracts
What autoimmune/delayed hypersensitivity results in swollen neurons with dense inflammatory cell infiltrated in the cauda equina that is most common in horses?

Cauda Equina Neuritis!
Possibily a delayed hypersensitivity to myelin components released in EHV-1 infection
Can lead to paralysis of the tail, bladder and anal sphincters

What brain tumor is indicated if a horse retains its winter coat?
Pituitary tumor

Cat. What is wrong with it? etiology?

Anterior uveitis
Etiology= FIP or ideopathic lymphoplasmacytic uveitis
Horse with hyperkeratotic plaque that spontaneously resolved.
Mdx? Etiology?

Aural Plaques
Etiology: maybe papilloma virus spread by flies
What neuron reaction to injury is seen below (shrunken cells, acidophilic, angular, pyknotic/abcent nucleus)?
What causes it?

Acidophilia
Ischemic change –> cell death (permanent)
Occur sin trauma, hypoglycaemia and thiamine deficiency
Where is the remtelination capacity greater: CNS or PNS?
PNS
T/F: Fibrinoid necrosis of vessels in the CNS causes a vasogenic edema?

True
———-
Causes: Renal failure, Ischemia, Hypertension, Sel/VitE, Vasculitis
In horses, what disease causes a loss of nerve fibers and ganglion cell layers, but excellent preservation of photoreceptors and outer nucelar layer of the eye?
Retinal atrophy due to glaucoma
ONLY type of retinal atrophy that can be differentiated on histology
T/F: Epicardial petechia/ecchymosis of the epicardium is always an indicator of endotoxemia/sepsis
FALSE- it can also just be an agonal change (developed during death)

Luxated lens
What anoxic producing situations can produce CCN?
- Avitaminosis E- chickens- vascular thrombosis from peroxidative damage to vascular endothelium
- Hypoxia – cardiac arrest
- Lead & salt posioning
What is the name of the inherited disease that results in bilaterally symmetrical foci/diffuse corneal edema, as a result of ideopathic endothelial degeneration with old age?

Corneal endothelial dystrophies
What endotheliotropic virus in horses result in a sudden onset of hindlimb ataxia due to vasculitis & infarction of the spinal cord and other parts of the CNS?

Equine Herpes Virus-1 (may see inclusion bodies)

What happens to a sheep if it ingest dog feces containing Taenia Multiceps eggs?
Coenuris cerebalis “circling disease”
Acute: parasite migration (tracts), malacia
Chronic: cysts large, compression, oedema, hydrocephalus, bone softening. Cerebrum most common location

gyral (transtentorial) herniation (herniation of parahippocampal gyri under the tentorium cerebelli) due to cerebral edema usally occur in ________

horses
Equine colon. Etiology?

Small Stongyles - Cyathostomins
Larvae encysted in mucosa, Adults in lumen
What is the fancy term for an end stage eye in a horse?
Phthisis bulbi
What disease in horses causes microscopic Degeneration and loss of motor neurons in ventral horns of spinal cord & Some degenration of neurons in brain nuclei?
Equine Motor Neuron Disease
What do you call lens-induced uveitis due to rupture of the lens?
Phacoclastic
What are three viral causes of keratits? what do they all have in common?
IBR, MCF, FHV-1
All are Herpes Virus!
T/F: Vasculitits and perivascular cuffing can be used interchangeably
False
Vasculitis is inflammation of the blood vessel wall- the vessel will contain inflammatory cells
Perivascular cuffing is movement/accumulation of inflammatory cells outside of vessels in the virchow robin space
If you have a dog with this abnormality, what endocrine dysfunction may you see?

pseudo-hyperparathyroidism due to production of PTH-RP
May have fibrous osteodystrophy, metastatic calcification, low PTH and parathyroid gland atrophy
What is gliosis?
***KNOW THIS***
Increase in cell density in an area of nervous tissue
Due to proliferation of cells (ie astrocytes) or influx of cells
What type of viruses cause viral vasculopathies/epitheloptrophic in bovine/equine/dogs? What about in cats?
HERPES!!!
Bovine- MCF (OvHV-2)/ Canine- CHV / Equine- EHV-1
&
Feline - Dry FIP = CORONAVIRUS
what term is used to describe inflammation of the eyelids?
Blepharitis
Which canine morbillivirus cause demyelinating encephalitis, oligiodendrocyte inclusion, myelin vacuolation, gliosis, lymphocytic perivascular cuffing, polioencephalitis, mucopurulent ocular dischrge, inflammation of mucosal surfaces, enamel hypoplasia, and foot pad hyperatosis “hard pad”?

Canine Distemper

What disease causes laminar vaculation (not necrosis), hypertrophy of astrocytes, cerebral edema at the grey/white matter junction and myelin edema? What are the causes in different species?

Hepatic Encephalopathy
Causes: **Chronic > Acute Liver Disease
- Cattle: ragworth poisoning
- Dogs- porto-systemic shunts
- Sheep- copper posioning –> massive hepatic necrosis
If the coreal in eroded, epithelial regeneration is ______
very rapid
What is the difference between primary and secondary cardiomyopathies?
Primary= ideopathic, either dilated (dogs), hypertrophic (cats) or restrictive (cats-rare)
Secondary- =associated with specific heart muscle disease

































































































